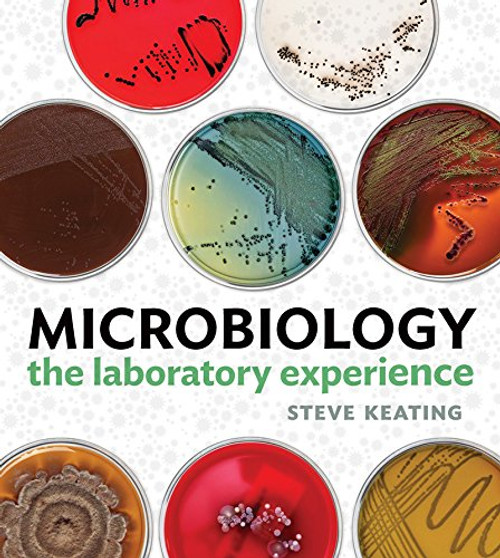
Microbiology: The Laboratory Experience Microbiology: The Laboratory Experience

Product Overview
Laboratory Exercises in Microbiology, Ninth Edition was designed and written to be directly correlated to Prescotts Microbiology, Ninth Edition, by Joanne M. Willey, Linda M. Sherwood, and Christopher J. Woolverton. The class-tested exercises are modular to allow instructors to easily incorporate them into their course.